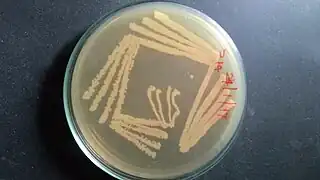

Micrococcales
Micrococcales es un orden de Actinomycetia. Son bacterias Gram-positivas que viven en el suelo, la piel de animales y gran variedad de hábitat.[1]
Kytococcus, bacteria cuya taxonomía no está clara, pudiendo adscribirse a Dermacoccaceae o Intrasporangiaceae.[2]
| Micrococcineae | ||
|---|---|---|
![]() | ||
| Taxonomía | ||
| Dominio: | Bacteria | |
| Filo: | Actinomycetota | |
| Clase: | Actinomycetia | |
| Orden: |
Micrococcocales Prévot 1940 (Listas Aprobadas 1980) | |
| Familias | ||
Beutenbergiaceae | ||
Referencias
- Euzéby JP, Parte AC. «Micrococcales». List of Prokaryotic names with Standing in Nomenclature (LPSN). Consultado el 15 de junio de 2021.
- Erko Stackebrandt & Peter Schumann 2014, The Family Dermacoccaceae Rosenberg E., DeLong E.F., Lory S., Stackebrandt E., Thompson F. (eds) The Prokaryotes. Springer, Berlin, Heidelberg
Este artículo ha sido escrito por Wikipedia. El texto está disponible bajo la licencia Creative Commons - Atribución - CompartirIgual. Pueden aplicarse cláusulas adicionales a los archivos multimedia.
